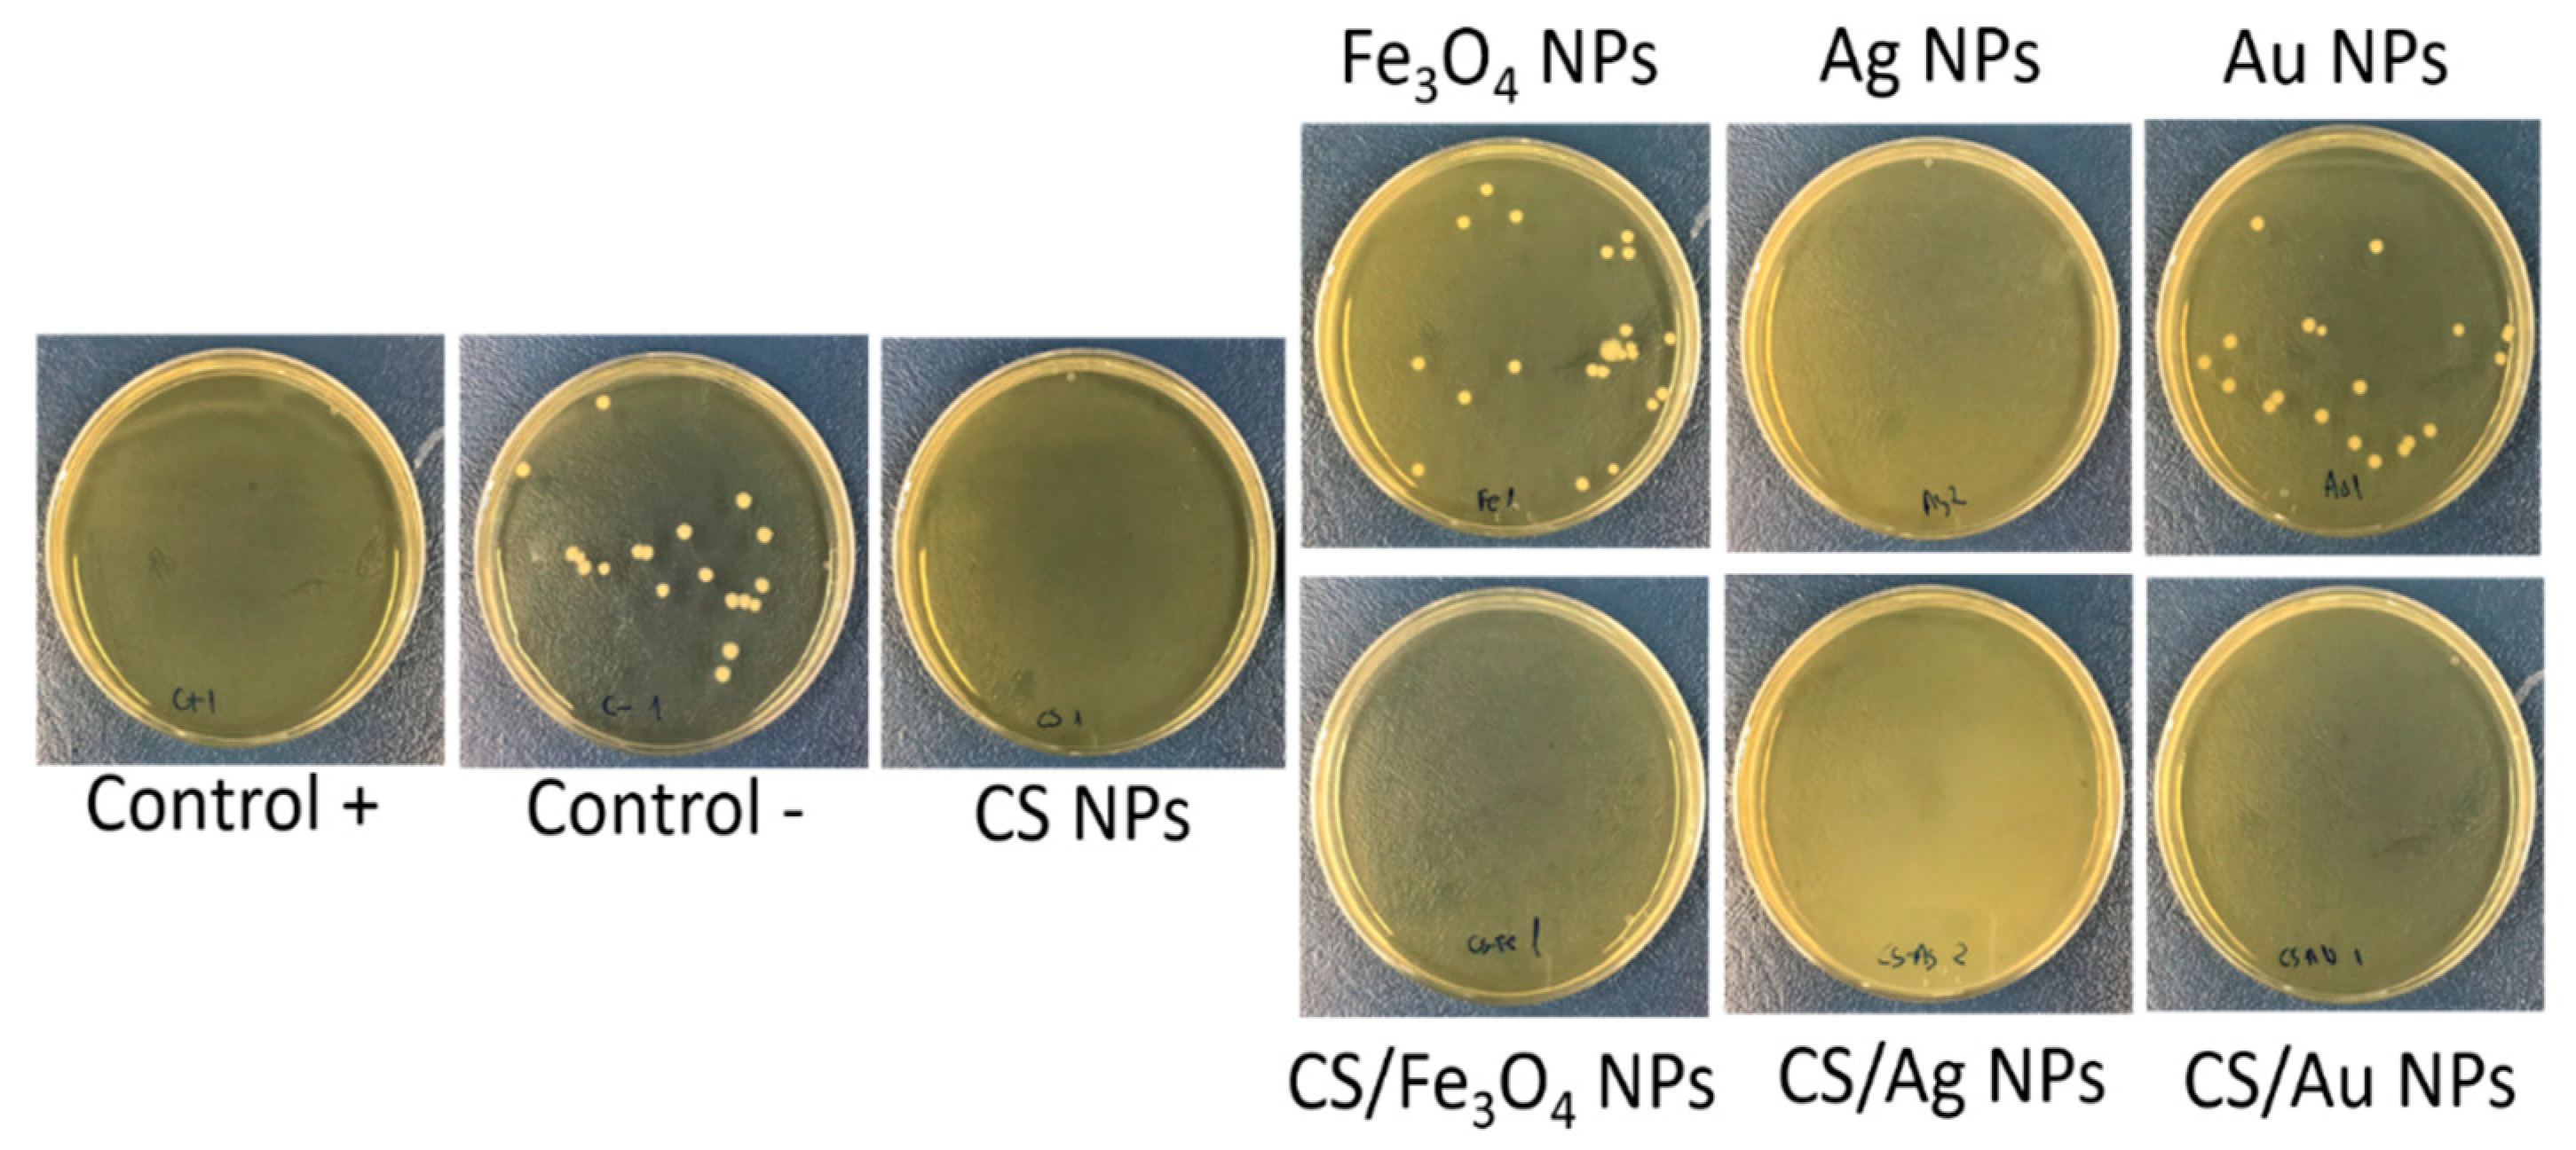
Polymers 13 03910 g005

Ionotropic Gelation-Based Synthesis of Chitosan-Metal Hybrid Nanoparticles Showing Combined Antimicrobial and Tissue Regenerative Activities
Abstract
:1. Introduction
2. Materials and Methods
2.1. Reagents
2.2. Nanoparticles Synthesis
2.2.1. Iron Oxide Nanoparticles
2.2.2. Silver Nanoparticles
2.2.3. Gold Nanoparticles
2.2.4. Chitosan Nanoparticles
2.2.5. Hybrid Nanoparticles
2.3. Nanoparticles Morphology, Size and Surface Zeta Potential Characterization
2.4. Fourier Transform Infrared (FTIR) Spectroscopy
2.5. Determination of Nanoparticles Synthesis Yield
2.6. Determination of Inorganic Nanoparticles Encapsulation
2.7. Inorganic Nanoparticles Quantification
2.8. Cell Viability Assay
2.9. Antibacterial Activity Test
2.10. Wound Healing Assay
3. Results and Discussion
3.1. Nanoparticles Preparation and Characterization
3.2. Cytotoxicity Tests
3.3. Antibacterial Activity Test
3.4. Wound Healing Assay
4. Conclusions
Supplementary Materials
Author Contributions
Funding
Institutional Review Board Statement
Informed Consent Statement
Data Availability Statement
Acknowledgments
Conflicts of Interest
References
- Pelaz, B.; Alexiou, C.; Alvarez-Puebla, R.A.; Alves, F.; Andrews, A.M.; Ashraf, S.; Balogh, L.P.; Ballerini, L.; Bestetti, A.; Brendel, C.; et al. Diverse applications of nanomedicine. ACS Nano 2017, 11, 2313–2381. [Google Scholar] [CrossRef]
- Marciello, M.; Pellico, J.; Fernandez-Barahona, I.; Herranz, F.; Ruiz-Cabello, J.; Filice, M. Recent advances in the preparation and application of multifunctional iron oxide and liposome-based nanosystems for multimodal diagnosis and therapy. Interface Focus 2016, 6, 20160055. [Google Scholar] [CrossRef]
- Erami, R.S.; Ovejero, K.; Meghdadi, S.; Filice, M.; Amirnasr, M.; Rodriguez-Dieguez, A.; de La Orden, M.U.; Gomez-Ruiz, S. Applications of nanomaterials based on magnetite and mesoporous silica on the selective detection of zinc ion in live cell imaging. Nanomaterials 2018, 8, 434. [Google Scholar] [CrossRef] [PubMed]
- Sanchez, A.; Ovejero Paredes, K.; Ruiz-Cabello, J.; Martinez-Ruiz, P.; Pingarron, J.M.; Villalonga, R.; Filice, M. Hybrid decorated core@ shell janus nanoparticles as a flexible platform for targeted multimodal molecular bioimaging of cancer. ACS Appl. Mater. Interfaces 2018, 10, 31032–31043. [Google Scholar] [CrossRef] [PubMed]
- Vinambres, M.; Filice, M.; Marciello, M. Modulation of the catalytic properties of lipase b from candida antarctica by immobilization on tailor-made magnetic iron oxide nanoparticles: The key role of nanocarrier surface engineering. Polymers 2018, 10, 615. [Google Scholar] [CrossRef]
- Filice, M.; Ruiz-Cabello, J. Nucleic Acid Nanotheranostics: Biomedical Applications; Elsevier: Amsterdam, The Netherlands, 2019. [Google Scholar]
- Ovejero Paredes, K.; Diaz-Garcia, D.; Garcia-Almodovar, V.; Lozano Chamizo, L.; Marciello, M.; Diaz-Sanchez, M.; Prashar, S.; Gomez-Ruiz, S.; Filice, M. Multifunctional silica-based nanoparticles with controlled release of organotin metallodrug for targeted theranosis of breast cancer. Cancers 2020, 12, 187. [Google Scholar] [CrossRef] [PubMed]
- Wang, L.; Marciello, M.; Estevez-Gay, M.; Soto Rodriguez, P.E.D.; Luengo Morato, Y.; Iglesias-Fernandez, J.; Huang, X.; Osuna, S.; Filice, M.; Sanchez, S. Enzyme conformation influences the performance of lipase-powered nanomotors. Angew. Chem. Int. Ed. Engl. 2020, 59, 21080–21087. [Google Scholar] [CrossRef]
- Seaberg, J.; Montazerian, H.; Hossen, M.N.; Bhattacharya, R.; Khademhosseini, A.; Mukherjee, P. Hybrid nanosystems for biomedical applications. ACS Nano 2021, 15, 2099–2142. [Google Scholar] [CrossRef]
- Taylor-Pashow, K.M.L.; Della Rocca, J.; Huxford, R.C.; Lin, W. Hybrid nanomaterials for biomedical applications. Chem. Commun. 2010, 46, 5832–5849. [Google Scholar] [CrossRef]
- Luengo Morato, Y.; Marciello, M.; Lozano Chamizo, L.; Ovejero Paredes, K.; Filice, M. Magnetic Nanoparticle-Based Hybrid Materials. Fundamentals and Applications. Cap 14: Hybrid Magnetic Nanoparticles for Multimodal Molecular Imaging of Cancer; Elsevier: Amsterdam, The Netherlands, 2021. [Google Scholar]
- Ferreira Soares, D.C.; Domingues, S.C.; Viana, D.B.; Tebaldi, M.L. Polymer-hybrid nanoparticles: Current advances in biomedical applications. Biomed. Pharmacother. 2020, 131, 110695. [Google Scholar] [CrossRef]
- Chouhan, D.; Dey, N.; Bhardwaj, N.; Mandal, B.B. Emerging and innovative approaches for wound healing and skin regeneration: Current status and advances. Biomaterials 2019, 216, 119267. [Google Scholar] [CrossRef] [PubMed]
- Kimura, S.; Tsuchiya, A.; Ogawa, M.; Ono, M.; Suda, N.; Sekimoto, K.; Takeo, M.; Tsuji, T. Tissue-scale tensional homeostasis in skin regulates structure and physiological function. Commun. Biol. 2020, 3, 637. [Google Scholar] [CrossRef] [PubMed]
- Bellu, E.; Medici, S.; Coradduzza, D.; Cruciani, S.; Amler, E.; Maioli, M. Nanomaterials in skin regeneration and rejuvenation. Int. J. Mol. Sci. 2021, 22, 7095. [Google Scholar] [CrossRef]
- Mohammadzadeh, L.; Mahkam, M.; Barzegari, A.; Karimi, A.; Kafil, H.S.; Salehi, R.; Rahbarghazi, R. Preparation, characterization, and antibacterial properties of hybrid nanofibrous scaffolds for cutaneous tissue engineering. Hum. Cell 2021, 34, 1682–1696. [Google Scholar] [CrossRef] [PubMed]
- Badawy, M.E.I.; Lotfy, T.M.R.; Shawir, S.M.S. Preparation and antibacterial activity of chitosan-silver nanoparticles for application in preservation of minced meat. Bull. Natl. Res. Cent. 2019, 43, 83. [Google Scholar] [CrossRef]
- Moreira, H.R.; Marques, A.P. Vascularization in skin wound healing: Where do we stand and where do we go? Curr. Opin. Biotechnol. 2022, 73, 253–262. [Google Scholar] [CrossRef]
- Wang, W.; Lu, K.-j.; Yu, C.-h.; Huang, Q.-l.; Du, Y.-Z. Nano-drug delivery systems in wound treatment and skin regeneration. J. Nanobiotechnol. 2019, 17, 82. [Google Scholar] [CrossRef]
- Sultankulov, B.; Berillo, D.; Sultankulova, K.; Tokay, T.; Saparov, A. Progress in the development of chitosan-based biomaterials for tissue engineering and regenerative medicine. Biomolecules 2019, 9, 470. [Google Scholar] [CrossRef]
- Zhao, D.; Yu, S.; Sun, B.; Gao, S.; Guo, S.; Zhao, K. Biomedical applications of chitosan and its derivative nanoparticles. Polymers 2018, 10, 462. [Google Scholar] [CrossRef]
- Rossi, S.; Marciello, M.; Sandri, G.; Bonferoni, M.C.; Ferrari, F.; Caramella, C. Chitosan ascorbate: A chitosan salt with improved penetration enhancement properties. Pharm. Dev. Technol. 2008, 13, 513–521. [Google Scholar] [CrossRef]
- Rossi, S.; Marciello, M.; Sandri, G.; Ferrari, F.; Bonferoni, M.C.; Papetti, A.; Caramella, C.; Dacarro, C.; Grisoli, P. Wound dressings based on chitosans and hyaluronic acid for the release of chlorhexidine diacetate in skin ulcer therapy. Pharm. Dev. Technol. 2007, 12, 415–422. [Google Scholar] [CrossRef] [PubMed]
- Feng, P.; Luo, Y.; Ke, C.; Qiu, H.; Wang, W.; Zhu, Y.; Hou, R.; Xu, L.; Wu, S. Chitosan-based functional materials for skin wound repair: Mechanisms and applications. Front. Bioeng. Biotechnol. 2021, 9, 650598. [Google Scholar] [CrossRef] [PubMed]
- Khalid, K.; Tan, X.; Mohd Zaid, H.F.; Tao, Y.; Lye Chew, C.; Chu, D.T.; Lam, M.K.; Ho, Y.C.; Lim, J.W.; Chin Wei, L. Advanced in developmental organic and inorganic nanomaterial: A review. Bioengineered 2020, 11, 328–355. [Google Scholar] [CrossRef]
- Li, X.; Wang, Y.; Shi, L.; Li, B.; Li, J.; Wei, Z.; Lv, H.; Wu, L.; Zhang, H.; Yang, B.; et al. Magnetic targeting enhances the cutaneous wound healing effects of human mesenchymal stem cell-derived iron oxide exosomes. J. Nanobiotechnol. 2020, 18, 113. [Google Scholar] [CrossRef]
- Branca, M.; Marciello, M.; Ciuculescu-Pradines, D.; Respaud, M.; Morales, M.d.P.; Serra, R.; Casanove, M.-J.; Amiens, C. Towards MRI T2 contrast agents of increased efficiency. J. Magn. Magn. Mater. 2015, 377, 348–353. [Google Scholar] [CrossRef]
- Kossatz, S.; Ludwig, R.; Dähring, H.; Ettelt, V.; Rimkus, G.; Marciello, M.; Salas, G.; Patel, V.; Teran, F.J.; Hilger, I. High therapeutic efficiency of magnetic hyperthermia in xenograft models achieved with moderate temperature dosages in the tumor area. Pharm. Res. 2014, 31, 3274–3288. [Google Scholar] [CrossRef] [PubMed]
- Lazaro-Carrillo, A.; Filice, M.; Guillén, M.J.; Amaro, R.; Viñambres, M.; Tabero, A.; Paredes, K.O.; Villanueva, A.; Calvo, P.; del Puerto Morales, M.; et al. Tailor-made PEG coated iron oxide nanoparticles as contrast agents for long lasting magnetic resonance molecular imaging of solid cancers. Mater. Sci. Eng. C 2020, 107, 110262. [Google Scholar] [CrossRef] [PubMed]
- Palma, S.I.; Carvalho, A.; Silva, J.; Martins, P.; Marciello, M.; Fernandes, A.R.; del Puerto Morales, M.; Roque, A.C. Covalent coupling of gum arabic onto superparamagnetic iron oxide nanoparticles for MRI cell labeling: Physicochemical and in vitro characterization. Contrast Media Mol. Imaging 2015, 10, 320–328. [Google Scholar] [CrossRef]
- Luengo Morato, Y.; Ovejero Paredes, K.; Lozano Chamizo, L.; Marciello, M.; Filice, M. Recent advances in multimodal molecular imaging of cancer mediated by hybrid magnetic nanoparticles. Polymers 2021, 13, 2989. [Google Scholar] [CrossRef]
- Yadav, E.; Yadav, P.; Verma, A. In silico study of trianthema portulacastrum embedded iron oxide nanoparticles on glycogen synthase kinase-3beta: A possible contributor to its enhanced in vivo wound healing potential. Front. Pharmacol. 2021, 12, 664075. [Google Scholar] [CrossRef]
- Ismail, R.A.; Sulaiman, G.M.; Abdulrahman, S.A.; Marzoog, T.R. Antibacterial activity of magnetic iron oxide nanoparticles synthesized by laser ablation in liquid. Mater. Sci. Eng. C Mater. Biol. Appl. 2015, 53, 286–297. [Google Scholar] [CrossRef]
- Saqib, S.; Munis, M.F.H.; Zaman, W.; Ullah, F.; Shah, S.N.; Ayaz, A.; Farooq, M.; Bahadur, S. Synthesis, characterization and use of iron oxide nano particles for antibacterial activity. Microsc. Res. Tech. 2019, 82, 415–420. [Google Scholar] [CrossRef] [PubMed]
- Friedrich, R.P.; Cicha, I.; Alexiou, C. Iron oxide nanoparticles in regenerative medicine and tissue engineering. Nanomaterials 2021, 11, 2337. [Google Scholar] [CrossRef]
- Nanda, T.; Alobaid, M.; Rege, K. Iron oxide nanoparticles for tissue repair and regeneration. Nano LIFE 2021, 11, 2030001. [Google Scholar] [CrossRef]
- Arakha, M.; Pal, S.; Samantarrai, D.; Panigrahi, T.K.; Mallick, B.C.; Pramanik, K.; Mallick, B.; Jha, S. Antimicrobial activity of iron oxide nanoparticle upon modulation of nanoparticle-bacteria interface. Sci. Rep. 2015, 5, 14813. [Google Scholar] [CrossRef] [PubMed]
- Burdusel, A.C.; Gherasim, O.; Grumezescu, A.M.; Mogoanta, L.; Ficai, A.; Andronescu, E. Biomedical applications of silver nanoparticles: An up-to-date overview. Nanomaterials 2018, 8, 681. [Google Scholar] [CrossRef] [PubMed]
- Gunasekaran, T.; Nigusse, T.; Dhanaraju, M.D. Silver nanoparticles as real topical bullets for wound healing. J. Am. Coll. Clin. Wound Spec. 2012, 3, 82–96. [Google Scholar] [CrossRef] [PubMed]
- Luengo, Y.; Sot, B.; Salas, G. Combining Ag and γ-Fe(2)O(3) properties to produce effective antibacterial nanocomposites. Colloids Surf. B Biointerfaces 2020, 194, 111178. [Google Scholar] [CrossRef]
- Nešporová, K.; Pavlík, V.; Šafránková, B.; Vágnerová, H.; Odráška, P.; Žídek, O.; Císařová, N.; Skoroplyas, S.; Kubala, L.; Velebný, V. Effects of wound dressings containing silver on skin and immune cells. Sci. Rep. 2020, 10, 15216. [Google Scholar] [CrossRef] [PubMed]
- Rozalen, M.; Sánchez-Polo, M.; Fernández-Perales, M.; Widmann, T.J.; Rivera-Utrilla, J. Synthesis of controlled-size silver nanoparticles for the administration of methotrexate drug and its activity in colon and lung cancer cells. RSC Adv. 2020, 10, 10646–10660. [Google Scholar] [CrossRef]
- Wang, L.; Hu, C.; Shao, L. The antimicrobial activity of nanoparticles: Present situation and prospects for the future. Int. J. Nanomed. 2017, 12, 1227–1249. [Google Scholar] [CrossRef]
- Abaza, S.F.; Elbialy, N.S.; Mohamed, N. Incorporating silver nanoshell-coated mesoporous silica nanoparticles improves physicochemical and antimicrobial properties of chitosan films. Int. J. Biol. Macromol. 2021, 189, 792–801. [Google Scholar] [CrossRef]
- Chen, Z.; Yuan, J.; Yu, Q.; Luo, Z.; Xie, C.; Zhang, K.; Tang, L.; Wang, H. High strength antibacterial membranes consisted of nanofibrous chitosan immobilized silver nanoparticles. J. Appl. Polym. Sci. 2021, 138. [Google Scholar] [CrossRef]
- Chen, X.; Zhang, H.; Yang, X.; Zhang, W.; Jiang, M.; Wen, T.; Wang, J.; Guo, R.; Liu, H. Preparation and application of quaternized chitosan- and agnps-base synergistic antibacterial hydrogel for burn wound healing. Molecules 2021, 26, 4037. [Google Scholar] [CrossRef]
- You, C.; Li, Q.; Wang, X.; Wu, P.; Ho, J.K.; Jin, R.; Zhang, L.; Shao, H.; Han, C. Silver nanoparticle loaded collagen/chitosan scaffolds promote wound healing via regulating fibroblast migration and macrophage activation. Sci. Rep. 2017, 7, 10489. [Google Scholar] [CrossRef] [PubMed]
- Bueno, R.; Marciello, M.; Moreno, M.; Sánchez-Sánchez, C.; Martinez, J.I.; Martinez, L.; Prats-Alfonso, E.; Guimerà-Brunet, A.; Garrido, J.A.; Villa, R.; et al. Versatile graphene-based platform for robust nanobiohybrid interfaces. ACS Omega 2019, 4, 3287–3297. [Google Scholar] [CrossRef]
- Shrestha, B.; Wang, L.; Zhang, H.; Hung, C.Y.; Tang, L. Gold nanoparticles mediated drug-gene combinational therapy for breast cancer treatment. Int. J. Nanomed. 2020, 15, 8109–8119. [Google Scholar] [CrossRef] [PubMed]
- Leu, J.G.; Chen, S.A.; Chen, H.M.; Wu, W.M.; Hung, C.F.; Yao, Y.D.; Tu, C.S.; Liang, Y.J. The effects of gold nanoparticles in wound healing with antioxidant epigallocatechin gallate and alpha-lipoic acid. Nanomedicine 2012, 8, 767–775. [Google Scholar] [CrossRef]
- Li, Q.; Lu, F.; Zhou, G.; Yu, K.; Lu, B.; Xiao, Y.; Dai, F.; Wu, D.; Lan, G. Silver inlaid with gold nanoparticle/chitosan wound dressing enhances antibacterial activity and porosity, and promotes wound healing. Biomacromolecules 2017, 18, 3766–3775. [Google Scholar] [CrossRef] [PubMed]
- Ahmed, T.A.; Aljaeid, B.M. Preparation, characterization, and potential application of chitosan, chitosan derivatives, and chitosan metal nanoparticles in pharmaceutical drug delivery. Drug Des. Devel. Ther. 2016, 10, 483–507. [Google Scholar] [CrossRef] [PubMed]
- Riegger, B.R.; Bäurer, B.; Mirzayeva, A.; Tovar, G.E.M.; Bach, M. A systematic approach of chitosan nanoparticle preparation via emulsion crosslinking as potential adsorbent in wastewater treatment. Carbohydr. Polym. 2018, 180, 46–54. [Google Scholar] [CrossRef]
- Orellano, M.S.; Longo, G.S.; Porporatto, C.; Correa, N.M.; Falcone, R.D. Role of micellar interface in the synthesis of chitosan nanoparticles formulated by reverse micellar method. Colloids Surf. A Physicochem. Eng. Asp. 2020, 599, 124876. [Google Scholar] [CrossRef]
- Zahraei, M.; Marciello, M.; Lazaro-Carrillo, A.; Villanueva, A.; Herranz, F.; Talelli, M.; Costo, R.; Monshi, A.; Shahbazi-Gahrouei, D.; Amirnasr, M.; et al. Versatile theranostics agents designed by coating ferrite nanoparticles with biocompatible polymers. Nanotechnology 2016, 27, 255702. [Google Scholar] [CrossRef]
- De la Presa, P.; Luengo, Y.; Multigner, M.; Costo, R.; Morales, M.P.; Rivero, G.; Hernando, A. Study of heating efficiency as a function of concentration, size, and applied field in γ-fe2o3 nanoparticles. J. Phys. Chem. C 2012, 116, 25602–25610. [Google Scholar] [CrossRef]
- Massart, R. Preparation of aqueous magnetic liquids in alkaline and acidic media. IEEE Trans. Magn. 1981, 17, 1247–1248. [Google Scholar] [CrossRef]
- Costo, R.; Bello, V.; Robic, C.; Port, M.; Marco, J.F.; Puerto Morales, M.; Veintemillas-Verdaguer, S. Ultrasmall iron oxide nanoparticles for biomedical applications: Improving the colloidal and magnetic properties. Langmuir 2012, 28, 178–185. [Google Scholar] [CrossRef] [PubMed]
- Yang, J.; Yin, H.; Jia, J.; Wei, Y. Facile synthesis of high-concentration, stable aqueous dispersions of uniform silver nanoparticles using aniline as a reductant. Langmuir 2011, 27, 5047–5053. [Google Scholar] [CrossRef] [PubMed]
- Bastus, N.G.; Comenge, J.; Puntes, V. Kinetically controlled seeded growth synthesis of citrate-stabilized gold nanoparticles of up to 200 nm: Size focusing versus Ostwald ripening. Langmuir 2011, 27, 11098–11105. [Google Scholar] [CrossRef] [PubMed]
- Marciello, M.; Rossi, S.; Caramella, C.; Remuñán-López, C. Freeze-dried cylinders carrying chitosan nanoparticles for vaginal peptide delivery. Carbohydr. Polym. 2017, 170, 43–51. [Google Scholar] [CrossRef]
- Calvo, P.; Remuñan-López, C.; Vila-Jato, J.L.; Alonso, M.J. Chitosan and chitosan/ethylene oxide-propylene oxide block copolymer nanoparticles as novel carriers for proteins and vaccines. Pharm. Res. 1997, 14, 1431–1436. [Google Scholar] [CrossRef]
- Calvo, P.; Remuñán-López, C.; Vila-Jato, J.L.; Alonso, M.J. Novel hydrophilic chitosan-polyethylene oxide nanoparticles as protein carriers. J. Appl. Polym. Sci. 1997, 63, 125–132. [Google Scholar] [CrossRef]
- Janes, K.A.; Calvo, P.; Alonso, M.J. Polysaccharide colloidal particles as delivery systems for macromolecules. Adv. Drug Deliv. Rev. 2001, 47, 83–97. [Google Scholar] [CrossRef]
- Scarabelli, L.; Sanchez-Iglesias, A.; Perez-Juste, J.; Liz-Marzan, L.M. A “Tips and tricks” practical guide to the synthesis of gold nanorods. J. Phys. Chem. Lett. 2015, 6, 4270–4279. [Google Scholar] [CrossRef] [PubMed]
- Fan, W.; Yan, W.; Xu, Z.; Ni, H. Formation mechanism of monodisperse, low molecular weight chitosan nanoparticles by ionic gelation technique. Colloids Surf. B Biointerfaces 2012, 90, 21–27. [Google Scholar] [CrossRef]
- Thandapani, G.; Prasad, S.; Sudha, P.N.; Sukumaran, A. Size optimization and in vitro biocompatibility studies of chitosan nanoparticles. Int. J. Biol. Macromol. 2017, 104, 1794–1806. [Google Scholar] [CrossRef]
- Rassu, G.; Porcu, E.P.; Fancello, S.; Obinu, A.; Senes, N.; Galleri, G.; Migheli, R.; Gavini, E.; Giunchedi, P. Intranasal delivery of genistein-loaded nanoparticles as a potential preventive system against neurodegenerative disorders. Pharmaceutics 2018, 11, 8. [Google Scholar] [CrossRef]
- Ahmed, S.B.; Mohamed, H.I.; Al-Subaie, A.M.; Al-Ohali, A.I.; Mahmoud, N.M.R. Investigation of the antimicrobial activity and hematological pattern of nano-chitosan and its nano-copper composite. Sci. Rep. 2021, 11, 9540. [Google Scholar] [CrossRef]
- Ali, M.E.A.; Aboelfadl, M.M.S.; Selim, A.M.; Khalil, H.F.; Elkady, G.M. Chitosan nanoparticles extracted from shrimp shells, application for removal of Fe(II) and Mn(II) from aqueous phases. Sep. Sci. Technol. 2018, 53, 2870–2881. [Google Scholar] [CrossRef]
- Jesus, S.; Marques, A.P.; Duarte, A.; Soares, E.; Costa, J.P.; Colaço, M.; Schmutz, M.; Som, C.; Borchard, G.; Wick, P.; et al. Chitosan nanoparticles: Shedding light on immunotoxicity and hemocompatibility. Front. Bioeng. Biotechnol. 2020, 8, 100. [Google Scholar] [CrossRef]
- Omidi, S.; Kakanejadifard, A. Modification of chitosan and chitosan nanoparticle by long chain pyridinium compounds: Synthesis, characterization, antibacterial, and antioxidant activities. Carbohydr. Polym. 2019, 208, 477–485. [Google Scholar] [CrossRef]
- Shawkat, S.M.; Al-Jawasim, M.; Khaleefah, L.S. Extending shelf life of pasteurized milk via chitosan nanoparticles. J. Pure Appl. Microbiol. 2019, 13, 2471. [Google Scholar] [CrossRef]
- Ing, L.Y.; Zin, N.M.; Sarwar, A.; Katas, H. Antifungal activity of chitosan nanoparticles and correlation with their physical properties. Int. J. Biomater. 2012, 2012, 632698. [Google Scholar] [CrossRef]
- Lustriane, C.; Dwivany, F.M.; Suendo, V.; Reza, M. Effect of chitosan and chitosan-nanoparticles on post harvest quality of banana fruits. J. Plant Biotechnol. 2018, 45, 36–44. [Google Scholar] [CrossRef]
- Des Jardins-Park, H.E.; Foster, D.S.; Longaker, M.T. Fibroblasts and wound healing: An update. Regen. Med. 2018, 13, 491–495. [Google Scholar] [CrossRef] [PubMed]
- Sengul, A.B.; Asmatulu, E. Toxicity of metal and metal oxide nanoparticles: A review. Environ. Chem. Lett. 2020, 18, 1659–1683. [Google Scholar] [CrossRef]
- Petkovsek, Z.; Elersic, K.; Gubina, M.; Zgur-Bertok, D.; Starcic Erjavec, M. Virulence potential of Escherichia coli isolates from skin and soft tissue infections. J. Clin. Microbiol. 2009, 47, 1811–1817. [Google Scholar] [CrossRef] [PubMed]
- Ali Khan, Z.; Jamil, S.; Akhtar, A.; Mustehsan Bashir, M.; Yar, M. Chitosan based hybrid materials used for wound healing applications—A short review. Int. J. Polym. Mater. Polym. Biomater. 2020, 69, 419–436. [Google Scholar] [CrossRef]

| Sample | CS/TPP Ratio (w/w) | Core Size (nm) | Hydrodynamic Size (nm) | PDI * | ζ-Potential (mV) pH 7 |
|---|---|---|---|---|---|
| CS NPs | 2.4/1 | 33.7 ± 5.85 | 109.8 | 0.19 | 8.1 |
| Fe3O4 NPs | - | 8.18 ± 1.57 | 19.98 | 0.18 | 3,6 |
| CS/Fe3O4 NPs | 2.6/1 | - | 123.1 | 0.12 | 7.5 |
| Ag NPs | - | 33.02 ± 13.02 | 108.2 | 0.29 | −11.8 |
| CS/Ag NPs | 2.5/1 | - | 121.8 | 0.22 | 7.7 |
| Au NPs | - | 14.05 ± 1.61 | 33.0 | 0.21 | −17.4 |
| CS/Au NPs | 2.5/1 | - | 121.5 | 0.30 | 7.5 |
| Sample | Inorganic NPs | Synthesis Yield (%) | Metal Encapsulation (%) | mg of Inorganic NPs in 1 mg/mL of Hybrid NPs | mg of CS in 1 mg of Hybrid NPs |
|---|---|---|---|---|---|
| CS NPs | - | 65 | - | - | 1 |
| CS/Fe3O4 NPs | Fe3O4 | 20 | 90.0 | 0.26 | 0.74 |
| CS/Ag NPs | Ag | 28 | 91.5 | 0.16 | 0.84 |
| CS/Au NPs | Au | 35 | 86.4 | 0.14 | 0.86 |
Publisher’s Note: MDPI stays neutral with regard to jurisdictional claims in published maps and institutional affiliations. |
© 2021 by the authors. Licensee MDPI, Basel, Switzerland. This article is an open access article distributed under the terms and conditions of the Creative Commons Attribution (CC BY) license (https://creativecommons.org/licenses/by/4.0/).
Share and Cite
Lozano Chamizo, L.; Luengo Morato, Y.; Ovejero Paredes, K.; Contreras Caceres, R.; Filice, M.; Marciello, M. Ionotropic Gelation-Based Synthesis of Chitosan-Metal Hybrid Nanoparticles Showing Combined Antimicrobial and Tissue Regenerative Activities. Polymers 2021, 13, 3910. https://doi.org/10.3390/polym13223910
Lozano Chamizo L, Luengo Morato Y, Ovejero Paredes K, Contreras Caceres R, Filice M, Marciello M. Ionotropic Gelation-Based Synthesis of Chitosan-Metal Hybrid Nanoparticles Showing Combined Antimicrobial and Tissue Regenerative Activities. Polymers. 2021; 13(22):3910. https://doi.org/10.3390/polym13223910
Chicago/Turabian StyleLozano Chamizo, Laura, Yurena Luengo Morato, Karina Ovejero Paredes, Rafael Contreras Caceres, Marco Filice, and Marzia Marciello. 2021. "Ionotropic Gelation-Based Synthesis of Chitosan-Metal Hybrid Nanoparticles Showing Combined Antimicrobial and Tissue Regenerative Activities" Polymers 13, no. 22: 3910. https://doi.org/10.3390/polym13223910
APA StyleLozano Chamizo, L., Luengo Morato, Y., Ovejero Paredes, K., Contreras Caceres, R., Filice, M., & Marciello, M. (2021). Ionotropic Gelation-Based Synthesis of Chitosan-Metal Hybrid Nanoparticles Showing Combined Antimicrobial and Tissue Regenerative Activities. Polymers, 13(22), 3910. https://doi.org/10.3390/polym13223910

